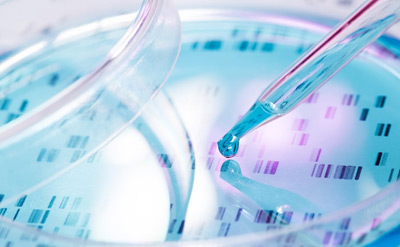

Giriş
Evinizdə qısa bir gəzintiyə çıxaq və həyatınızı asanlaşdıracaq nə qədər çox şeyin əvvəlcədən düşünülərək istifadənizə təqdim edildiyini bir düşünək... Hələ siz qapıdan addımınızı atmadan ayaqlarınızı silmək üçün yerləşdirilmiş ayaqaltı, içəri girdiyinizdə paltonuzu və ya pencəyinizi asacağınız bir asılqan, ayaqqabılarınızı qoyacağınız bir ayaqqabı yeri hazır vəziyyətdədir. Salonda oturacaqlar, xalça, pərdə, televizor kimi estetik və istifadəsindən rahatlığı düşünülərək yerləşdirilmiş əşyalar; mətbəxdə soyuducu, soba, içi bir çox lazımlı məmulatla dolu olan şkaflar tam ehtiyacınızı qarşılayacaq şəkildə hazır olarlar. Eyni şəkildə iş masası, lampa, qarderob və kitab rəfi... Hamısının yerbəyer edilməsinin məqsədi vardır.
Heç kim nə bu əşyaların təsadüfən meydana gəldiyini, nə də öz-özlərinə yerbəyer olduqlarını iddia edə bilməz. Bəhsi keçən əşya istər duzqabı kimi kiçik bir əşya olsun, istərsə də divardan asılmış dümdüz bir ayna olsun, hər kəs fikir birliyiylə bunların bir dizayn məhsulu olduğunu və şüurlu bir şəkildə yerbəyer edildiklərini qəbul edəcək. Üzərində düşünülərək, ağıl, bacarıq işlədilərək, müəyyən bir ehtiyaca istiqamətli, xüsusi bir məqsədlə hazırlandığı və yerbəyer edildiyi məlum olan bu əşyaları təsadüflərlə izah etməyə çalışmaq, son dərəcə məntiqsiz olacaq. Bu, ağıl sahibi hər insanın təsdiqləyəcəyi açıq bir həqiqətdir.
Ancaq mövzu canlılardakı dizayn olduqda, bəzi insanlar bu həqiqətə qarşı çıxaraq böyük bir məntiqsizlik sərgiləyərlər. Bu insanlar ən qabaqcıl texnologiyayla, ən inkişaf etmiş laboratoriyalarda və illərlə qazanılmış biliklərlə belə bənzəri yaradıla bilməmiş bir canlı hüceyrəsinin şüursuz təsadüflərin milyonlarla il üzərində işləməsi nəticəsində ortaya çıxdığını iddia edirlər. Heç bir elmi əsası olmayan bu iddianı müdafiə etmələrinin səbəbi isə, Darvinin təkamül nəzəriyyəsinə kor-koranə inanmalarıdır.
Halbuki, təkamül nəzəriyyəsi paleontologiya, populyasiya genetikası, müqayisəli anatomiya və ya müşahidə biologiyası kimi sahələrdə çökdüyü kimi, həyatın mənşəyini öyrənən molekulyar biologiya sahəsində də çökmüş vəziyyətdədir. Təkamül nəzəriyyəsinin "həyat təsadüflərin və təbiət qanunlarının məhsuludur" şəklində yekunlaşdırılan iddiası, daha hüceyrə mərhələsinə gəlmədən, molekulyar səviyyədə çıxılmaz vəziyyətə düşür.
Kitab boyunca verilən məlumatlarla hüceyrənin mürəkkəb quruluşlarından yalnız biri olan hüceyrə membranının üstün bir ağılın məhsulu olduğunu görəcək və nazik bir pərdənin belə təkamülçülərin təsadüf iddialarını tək başına necə etibarsız etdiyinə şahid olacaqsınız.
Ağıllı dizayn, yəni yaradılış
Kitabda vaxtaşırı qarşınıza Allahın yaratmasındakı mükəmməlliyi vurğulamaq üçün istifadə etdiyimiz "dizayn" sözü çıxacaq. Bu sözün hansı məqsədlə istifadə edildiyinin doğru başa düşülməsi çox əhəmiyyətlidir. Allahın bütün kainatda qüsursuz bir dizayn yaratmış olması Rəbbimizin əvvəl planlaşdırıb daha sonra yaratdığı mənasını verməz. Bilinməlidir ki, yerlərin və göylərin Rəbbi olan Allahın yaratmaq üçün hər hansı bir “dizayn” etməyə ehtiyacı yoxdur. Allahın dizaynı və yaratması eyni anda olur. Allah bu cür nöqsanlardan münəzzəhdir. Allah bir şeyin və ya bir işin olmasını istədikdə onun olması üçün Allahın yalnız "Ol!" deməsi kifayətdir. Ayələrdə belə buyrulur:
Bir şeyi yaratmaq istədikdə ona təkcə: “Ol!” deyər, o da olar. (Yasin surəsi, 82)
Göyləri və yeri icad edən Odur. O, bir işi yaratmaq istədikdə ona ancaq: “Ol!” – deyər, o da olar. (Bəqərə surəsi, 117)
Bənzər saytlar

Hüceyrə
membranındakı möcüzə



